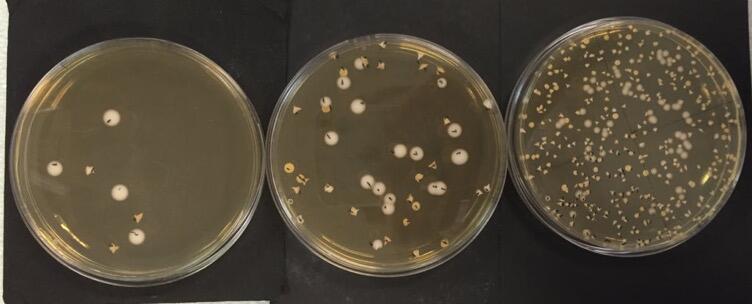

CPGE TB
Technologie et Biologie
Contact : cpge.tb@encpb.org
Vous voulez découvrir la CPGE TB ?
Envie de discuter avec des étudiants et des enseignants ?
N'hésitez pas à prendre contact avec nous pour faire un stage de découverte !
This email address is being protected from spambots. You need JavaScript enabled to view it.
Les équipes pédagogiques des 8 classes préparatoires TB (Technologie-Biologie) de France organisent une présentation de la filière TB.
Cette présentation s’adresse à tous les élèves de première et terminale STL (Biotech et SPCL) et STAV ainsi qu’à l’ensemble des membres des équipes pédagogiques, aux parents d'élèves et aux conseillers d’orientation. Les objectifs sont de présenter la formation, ses débouchés, le devenir de nos anciens étudiants, et de répondre aux questions et aux éventuelles inquiétudes des élèves à propos de la classe préparatoire TB. Il s'agit aussi de lever l'autocensure et de montrer que la CPGE TB est accessible à de nombreux élèves et permet de réaliser de très beaux parcours.
Jeudi 8 janvier 2026 de 18h à 19h30
Lien Teams de l'appel vidéo : Présentation de la CPGE TB
Numéro de réunion : 317 877 279 059 86
Code secret : EN6eb2Ly
La CPGE TB (Technologie, Biologie) prépare en deux ans aux concours communs voie A-TB d’admission dans les Écoles d’Ingénieurs en sciences du vivant et de l’environnement, dans les Écoles Nationales Vétérinaires, ainsi qu’à l’École Normale Supérieure (ENS) de Paris-Saclay.
Les concours A-TB sont réservés aux bacheliers technologiques (STL et STAV).
- OBJECTIFS DE LA FORMATION
La préparation aux concours est fondée sur une formation équilibrée à dominante scientifique dans les grands domaines suivants : biotechnologies, sciences de la vie et de la terre, mathématiques - informatique - physique - chimie. Des humanités (français-philosophie, géographie et langues vivantes) viennent compléter la formation. La préparation vise à développer les compétences pour une poursuite d’étude réussie :
- acquérir des connaissances scientifiques et technologiques solides ;
- pratiquer la démarche scientifique ;
- développer l’esprit critique ;
- maîtriser l’expression écrite et orale
- PUBLIC VISE
- POURQUOI L'ENCPB ?
- CONCOURS ET ECOLE PRESENTES
- RESULTATS
- DES PARCOURS VARIES
Le coeur de la formation
- Biotechnologies Elles abordent les techniques, les méthodes, et les procédés utilisant des systèmes biologiques en vue de la production de biens et de services. Elles s’appuient sur des disciplines fondamentales et appliquées : microbiologie, génie génétique, biochimie, génie enzymatique
- Sciences de la vie et de la Terre
- Mathématiques - informatique - physique - chimie
- Humanités (français/philosophie, géographie, langue vivante)
- Entrainements : colles et devoirs